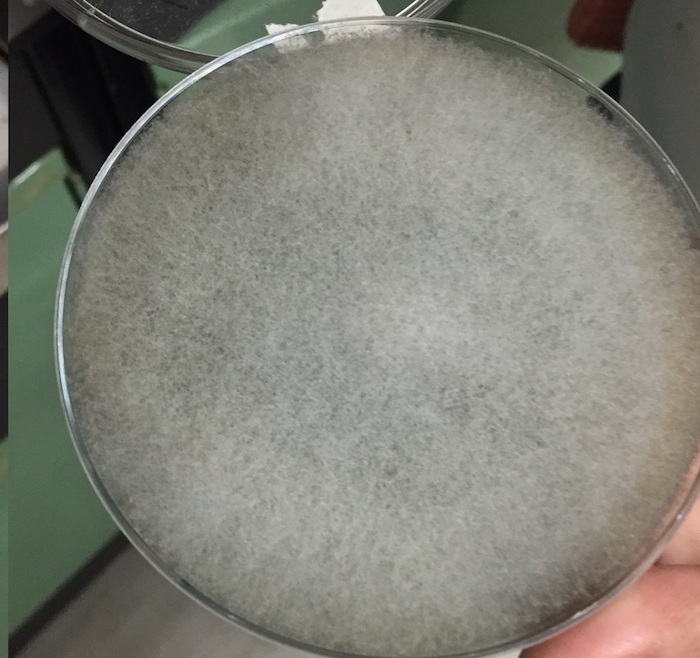

Un grupo de investigadores mexicanos busca usar residuos agroindustriales, como lo que sobra de la piña, como coagulante para la producción de quesos y así reducir gastos y evitar sacrificio de animales.
Por Dioreleytte Valis
Ciudad de México, 30 de junio (SinEmbargo/AgenciaConacyt).– Una serie de proyectos enfocados en el aprovechamiento de desechos agroindustriales, dirigidos por especialistas del Instituto Tecnológico Superior de Tierra Blanca (ITSTB) —perteneciente al Tecnológico Nacional de México (Tecnm)—, generó investigación orientada a la producción de cuajo microbiano a partir de la corona de la piña. La producción de estas enzimas o cuajo microbiano es importante para la manufactura de quesos, ya que brinda la textura, aroma y sabor característico del queso.
La investigación es parte del proyecto Aprovechamiento integral de residuos agroindustriales de la Cuenca del Papaloapan de Cátedras Conacyt, a cargo de los doctores Ricardo Hernández, Manuel Lizardi y Tannia Quiñones, que se encuentran comisionados en el ITSTB, en colaboración con la doctora Elizabeth Varela Santos.
Con el proyecto de Cátedras Conacyt, los especialistas se han encargado de estudiar los desechos agroindustriales de la región y su potencial biotecnológico, ejemplo de ellos son el bagazo de caña de azúcar, residuo de vainilla y la corona de la piña.
El proyecto planteado por los investigadores del ITSTB propone el uso de la corona de la piña para la obtención de enzimas proteolíticas que permiten la hidrólisis de la proteína de la leche. De acuerdo con la información expuesta por los investigadores, el residuo de la piña fue elegido para la producción de proteasas, gracias a que presentó mayor crecimiento de metabolitos.
¿QUÉ ES EL CUAJO MICROBIANO?
El doctor en biotecnología Ricardo Hernández Martínez explicó que el cuajo microbiano es un líquido o sólido que contiene enzimas proteolíticas que hidrolizan la proteína de la leche (caseína), es decir, se encargan de producir la cuajada en la leche. Estas enzimas, que conforman el cuajo microbiano, pueden ser obtenidas de plantas, animales y microorganismos, y pueden ser del tipo renina, quimosina y cardosina.
“La función de las enzimas es hidrolizar la caseína para obtener péptidos, la caseína al momento que es hidrolizada o transformada en péptidos se precipita, lo cual da como resultado el cuajado de la leche”.
Detalló también que los residuos agroindustriales están compuestos por moléculas que los microorganismos metabolizan y como parte del proceso pueden producir proteasas. Esto sucede principalmente con aquellos residuos que contienen proteína, debido a que estas moléculas pueden actuar como inductores para la producción de las enzimas, que dan lugar al cuajo microbiano.
Para el equipo de investigadores interesados en estudiar y generar usos alternativos de los desechos agroindustriales, la producción de este tipo de metabolitos conlleva a procesos más económicos y con menor daño ambiental, debido a que brinda un valor agregado a materia que habitualmente no se utiliza y que es parte de la contaminación ambiental.
“Una de las ventajas de utilizar como fuente de cultivo residuos agroindustriales para la fermentación en estado sólido es el beneficio económico, al valorizar la biomasa que no se utiliza para ningún fin”, enfatizó Javier Ricardo Díaz, colaborador del proyecto.
Debido a la especificidad de las enzimas que contiene el cuajo microbiano, los péptidos que se generan en la cuajada (hidrólisis de caseína) son homogéneos, e incluso son los compuestos responsables del aroma y sabor propio del producto.
LA PRODUCCIÓN DE QUESO

En la industria manufacturera de quesos, los coagulantes son de suma importancia. Hace algunas décadas, el coagulante para la producción de quesos era obtenido del estómago de terneras, lo que implicaba el sacrificio de animales. El cuajo de origen vegetal surge como segunda opción y con gran éxito, debido a las distintas fuentes de la que puede ser derivado, tales como el cardo y la leche de higuera. Entre las desventajas del cuajo vegetal se enumeran la inestabilidad y baja cantidad que se puede obtener de la materia prima.
Actualmente, el cuajo microbiano es el más utilizado gracias a sus ventajas sobre el cuajo animal y vegetal, entre ellas sobresalen su alta actividad de cuajado, estabilidad elevada y que los microorganismos son susceptibles a la manipulación genética, con lo cual se controlan las cantidades a producir, hasta la estabilidad de las proteasas contenidas en el cuajo.
Regularmente, es utilizada la fermentación por medio líquido para la obtención de cuajo microbiano, lo que resulta en costos elevados para la industria, es por ello que surge la fermentación en estado sólido como una alternativa viable.
“En la actualidad, los bioprocesos en estado sólido son poco utilizados a nivel industrial; sin embargo, debido a que se utilizan residuos agroindustriales como sustrato para los microorganismos en las fermentaciones, la fermentación en medio sólido se convierte en una opción adecuada para generar procesos de producción a bajo costo”, detalló el ingeniero Javier Ricardo Díaz.
Javier Ricardo Díaz es estudiante de la maestría en ciencias de los alimentos y biotecnología del ITSTB, perteneciente al Programa Nacional de Posgrados de Calidad (PNPC), y desarrolla la investigación denominada Producción de coagulantes para la industria quesera utilizando hongos filamentosos y residuos agroindustriales como soporte/sustrato, como parte de su proyecto de tesis.
Su investigación dio inicio con la valoración de tres residuos agroindustriales generados en la región: residuo de vainilla, bagazo de caña y corona de piña. Para la elección de la materia orgánica, fue necesario realizar pruebas de crecimiento en el laboratorio, en donde la corona de piña resultó la materia prima destinada a la producción de proteasas en un sistema de fermentación en estado sólido.
“Los procesos en fermentación sólida suelen requerir menos energía que su contraparte líquida, traduciéndose en menores costos de producción. Por otro lado, utilizar biomasa tiene efectos positivos al ambiente, ya que los residuos son fuentes contaminantes que pueden provocar daños a suelos, cuerpos de agua y aire”.
El experto agregó que la fermentación en estado sólido emergió como una alternativa porque presenta ventajas sobre la fermentación en medio líquido, entre las que destacan la producción más concentrada y mayor estabilidad térmica.
Los investigadores trabajan con los resultados preliminares para, posteriormente, buscar el vínculo con el sector productivo y así generar propuestas en conjunto.
APROVECHAMIENTO DE RESIDUOS
De acuerdo con datos de la Secretaría de Agricultura, Ganadería, Desarrollo Rural, Pesca y Alimentación (Sagarpa), Veracruz se posiciona como el estado líder en producción de piña (Ananas comosus), al aportar 70 por ciento de la producción nacional del fruto. Cada año se cosechan 545 mil 730 toneladas, que corresponden a 31 mil hectáreas sembradas.
El proyecto representa una alternativa para los productores de piña y para las industrias alimenticias que deseen el uso íntegro de la materia prima. Tradicionalmente, después de utilizar la pulpa de la piña, la cáscara y el corazón del fruto son usados para la fabricación de comida para mascotas, vinagre y alcohol. Sin embargo, la corona de la piña es una de las partes que queda obsoleta para usos posteriores.
El proyecto Aprovechamiento integral de residuos agroindustriales de la Cuenca del Papaloapan dirigido por los catedráticos Conacyt Ricardo Hernández, Manuel Lizardi y Tannia Quiñones, tiene por cometido desarrollar investigaciones y procesos que beneficien al sector productivo del entorno, además de la proposición de tecnologías que favorezcan al medio ambiente.



















































